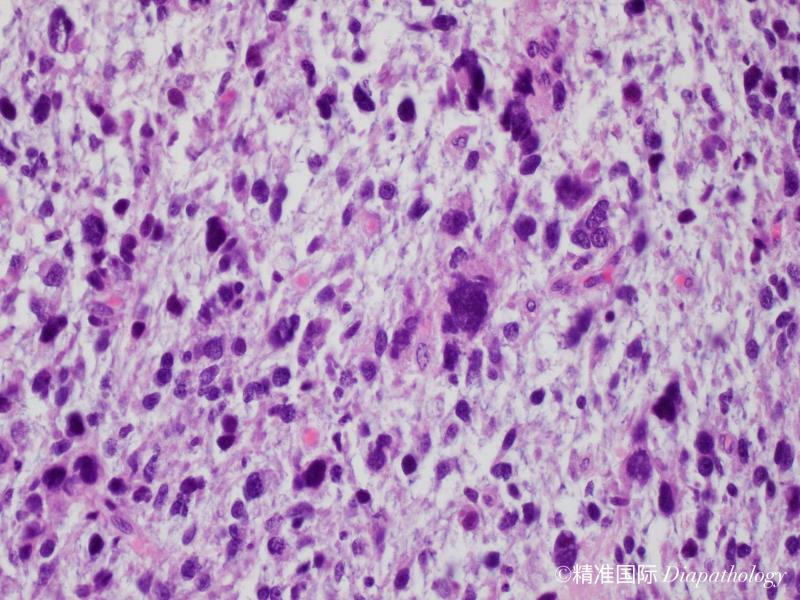
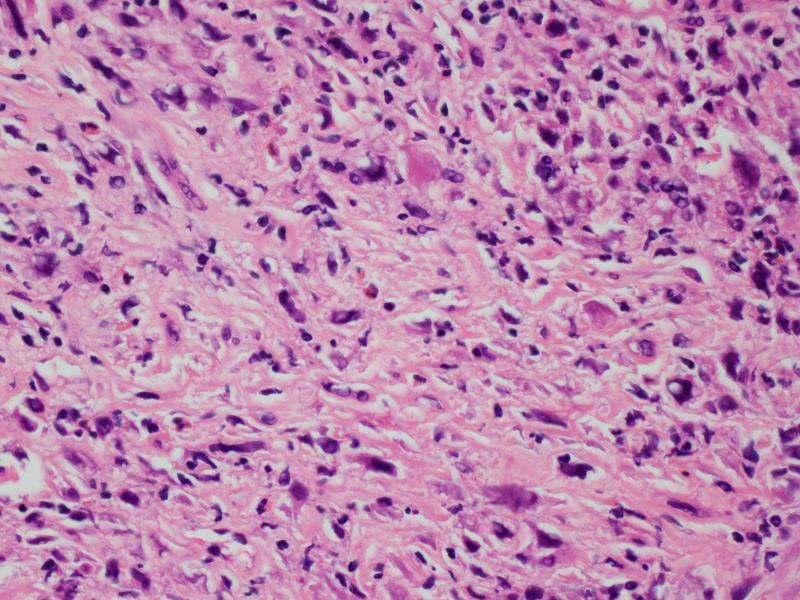
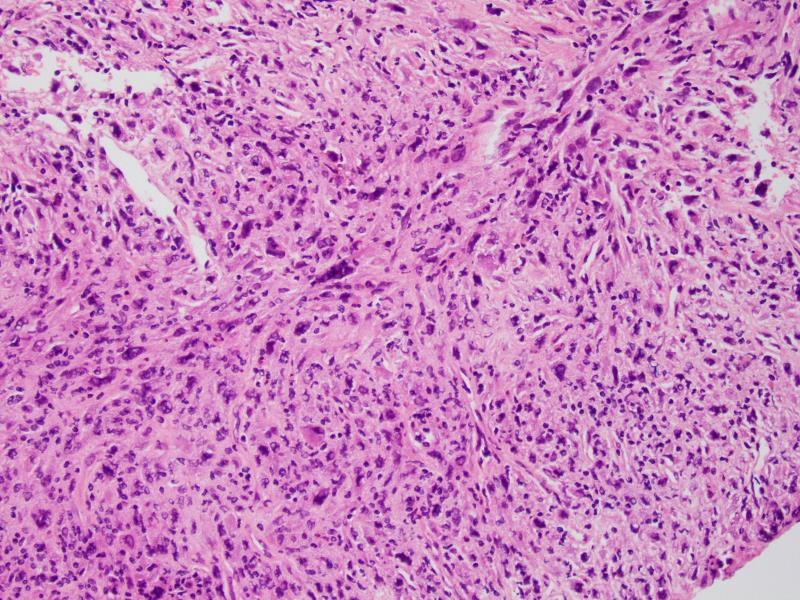
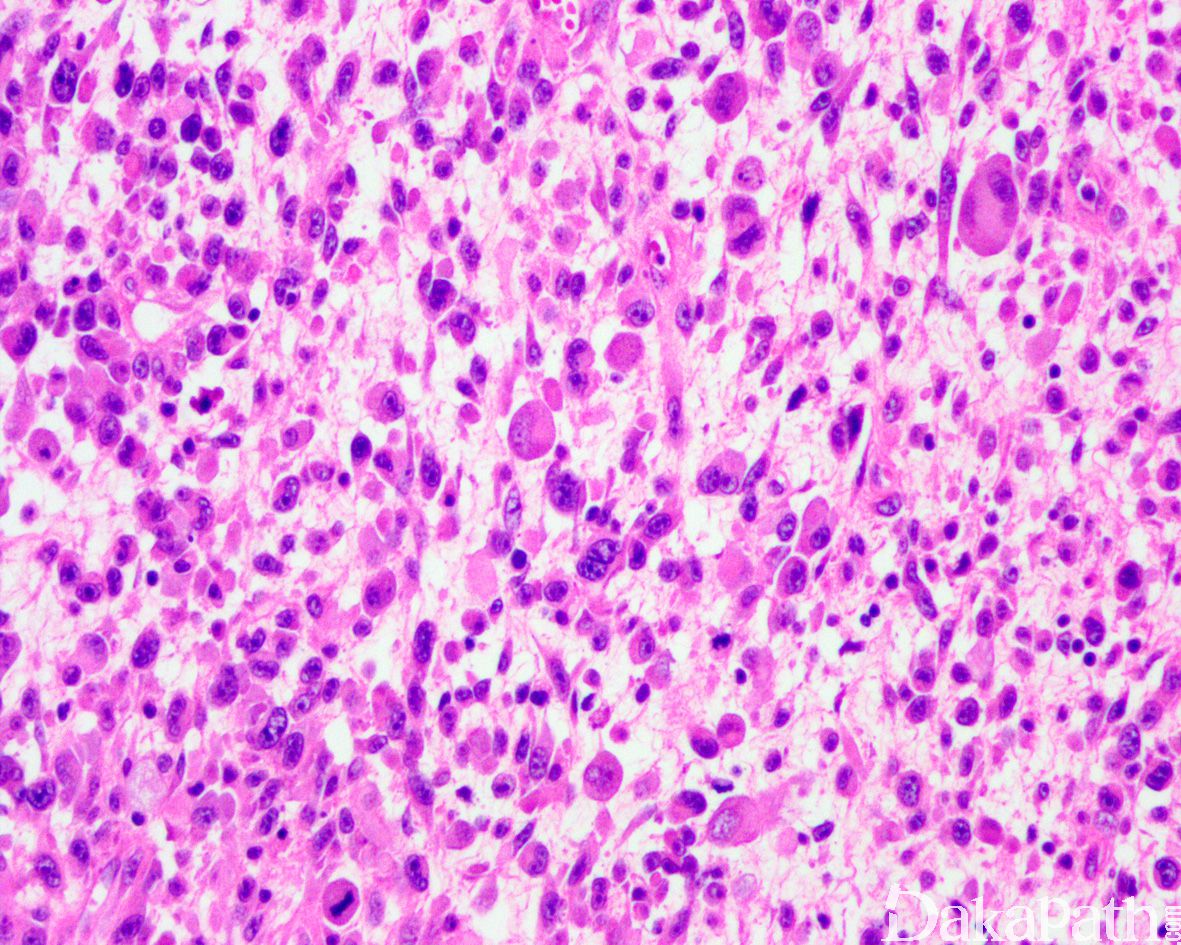
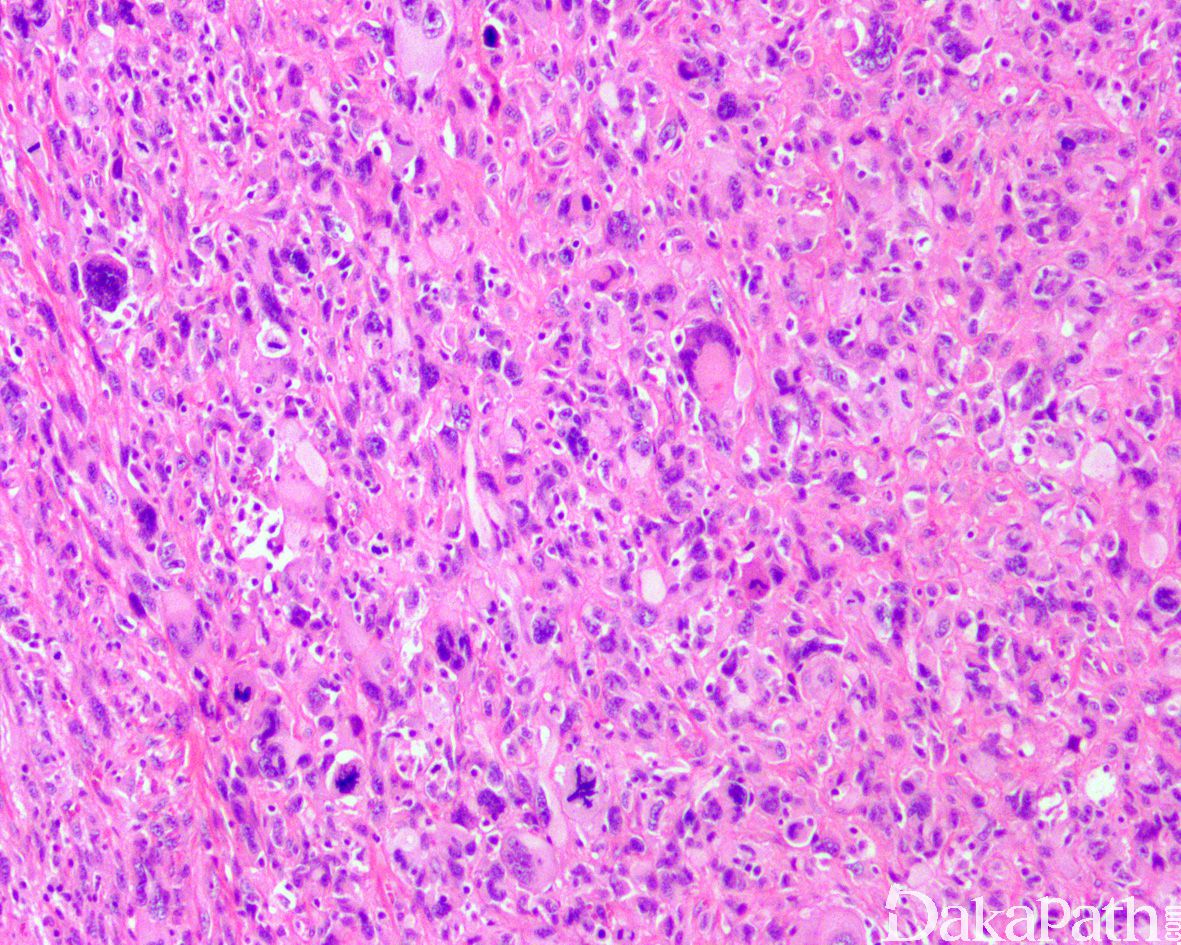
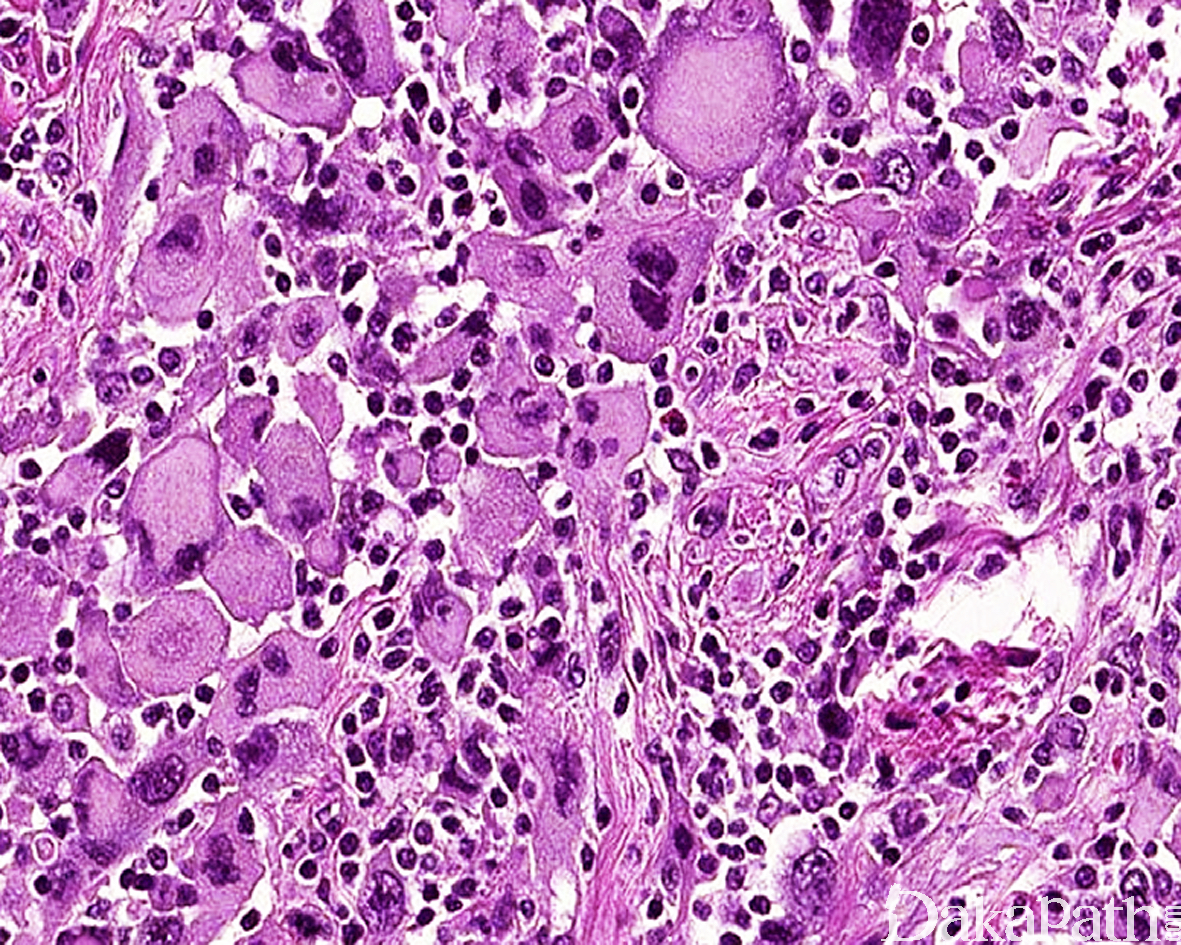

多形性横纹肌肉瘤
Pleomorphic Rhabdomyosarcoma,PRMS
概述:
显示多形性瘤细胞特征的横纹肌肉瘤亚型
发病部位: 好发于肢体深部软组织,尤其是大腿
诊断要点:
多发生于 45 岁以上的中老年人,偶可发生于儿童,常见于下肢,尤其是大腿,肿瘤界限相对清楚;
镜下见肿瘤由异型性明显的圆形、多边形深嗜酸性的细胞和一些小的未分化细胞及梭形细胞混合组成;
有些病例见梭形细胞呈束状或不规则状排列,偶尔可呈席纹状排列;部分病例还可见血管外皮瘤样排列;
部分细胞呈蝌蚪状、带状或网球拍状,胞质呈深嗜伊红色,外形不规则,一些细胞大而畸形,具深伊红色胞浆,这类细胞具有诊断价值;
少数病例瘤细胞胞质丰富,因中间丝聚集在核旁而呈包涵体样,核大,圆形和卵圆形,常偏位,染色质空泡状,可见明显的核仁;
部分区域可见瘤巨细胞或多核巨细胞,类似多形性未分化肉瘤;
肿瘤内常见坏死灶,核分裂象活跃。

免疫组织化学染色:
desmin 弥漫阳性,SMA、MyoD1 和 myogenin 阳性(有时可能很局灶),CK、S100. CD34 一般为阴性。
分子标记:
复杂的染色体核仁,无特异性的分子异常
鉴别诊断:
间变性横纹肌肉瘤 :除间变性区域外,多能见到经典的胚胎性横纹肌肉瘤或腺泡状横纹肌肉瘤区域。
未分化多形性肉瘤:大的嗜伊红胞质多呈一致的细小空泡状;肿瘤内常含有泡沫样组织细胞、破骨样多核巨细胞和炎症细胞等成分;desmin 常局灶弱阳性,MSA、MyoD1. myogenin 等阴性。
多形性脂肪肉瘤:多形性脂肪母细胞,表达 S100 蛋白。
多形性平滑肌肉瘤:通常可见局灶分化好的平滑肌肉瘤成分,免疫组化染色表达 SMA、desmin 和 H-caldesmon,不表达 MyoD1 和 myogenin.
去分化脂肪肉瘤:常见于腹膜后,肢体亦可发生;仔细取材周围常可见高分化脂肪肉瘤成分,瘤细胞弥漫表达 P16,CDK4 和 MDM2,遗传学上显示 MDM2 基因扩增。
预后:
预后差,70%以上的患者在 5 年内死于肿瘤转移,肺是最常见的远处转移部位。
治疗:
高度恶性肉瘤,应给予积极的综合性治疗。
参考文献:
Stock N, Chibon F, Binh MB, Terrier P, Michels JJ, Valo I, et al. Adulttype rhabdomyosarcoma: analysis of 57 cases with clinicopathologic description, identification of 3 morphologic patterns and prognosis. Am J Surg Pathol. 2009;33:1850–9. Li G, Ogose A, Kawashima H, et al. Cytogenetic and real-time quantitative reverse-transcriptase polymerase chain reaction analyses in pleomorphic rhabdomyosarcoma. Cancer Genet Cytogenet 2009; 192(1):1–9.
